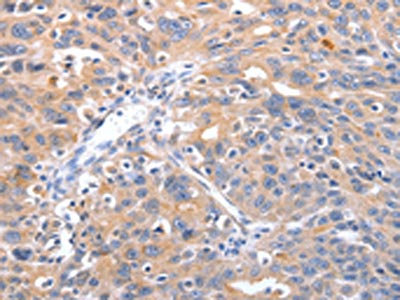

RCHY1 Antibody
-
中文名稱:RCHY1兔多克隆抗體
-
貨號:CSB-PA899249
-
規格:¥1100
-
圖片:
-
The image on the left is immunohistochemistry of paraffin-embedded Human ovarian cancer tissue using CSB-PA899249(RCHY1 Antibody) at dilution 1/30, on the right is treated with fusion protein. (Original magnification: ×200)
-
The image on the left is immunohistochemistry of paraffin-embedded Human lung cancer tissue using CSB-PA899249(RCHY1 Antibody) at dilution 1/30, on the right is treated with fusion protein. (Original magnification: ×200)
-
-
其他:
產品詳情
-
Uniprot No.:
-
基因名:
-
別名:Androgen receptor N terminal interacting protein antibody; Androgen receptor N-terminal-interacting protein antibody; ARNIP antibody; CH-rich-interacting match with PLAG1 antibody; CHIMP antibody; E3 ubiquitin-protein ligase Pirh2 antibody; hARNIP antibody; hPirh2 antibody; p53 induced protein with a RING H2 domain antibody; p53-induced RING-H2 protein antibody; PIRH2E antibody; PIRH2F antibody; PRO1996 antibody; RCHY1 antibody; Ring finger and CHY zinc finger domain containing 1 E3 ubiquitin protein ligase antibody; RING finger and CHY zinc finger domain-containing protein 1 antibody; RING finger protein 199 antibody; RNF199 antibody; ZCHY antibody; ZFP 363 antibody; zinc finger CHY type antibody; Zinc finger protein 363 antibody; ZN363_HUMAN antibody; ZNF363 antibody
-
宿主:Rabbit
-
反應種屬:Human,Mouse
-
免疫原:Fusion protein of Human RCHY1
-
免疫原種屬:Homo sapiens (Human)
-
標記方式:Non-conjugated
-
抗體亞型:IgG
-
純化方式:Antigen affinity purification
-
濃度:It differs from different batches. Please contact us to confirm it.
-
保存緩沖液:-20°C, pH7.4 PBS, 0.05% NaN3, 40% Glycerol
-
產品提供形式:Liquid
-
應用范圍:ELISA,IHC
-
推薦稀釋比:
Application Recommended Dilution ELISA 1:1000-1:5000 IHC 1:25-1:100 -
Protocols:
-
儲存條件:Upon receipt, store at -20°C or -80°C. Avoid repeated freeze.
-
貨期:Basically, we can dispatch the products out in 1-3 working days after receiving your orders. Delivery time maybe differs from different purchasing way or location, please kindly consult your local distributors for specific delivery time.
-
用途:For Research Use Only. Not for use in diagnostic or therapeutic procedures.
相關產品
靶點詳情
-
功能:Mediates E3-dependent ubiquitination and proteasomal degradation of target proteins, including p53/TP53, P73, HDAC1 and CDKN1B. Preferentially acts on tetrameric p53/TP53. Monoubiquitinates the translesion DNA polymerase POLH. Contributes to the regulation of the cell cycle progression. Increases AR transcription factor activity.
-
基因功能參考文獻:
- High Pirh2 expression was positively correlated with high tumor grade in brain glioma specimens. PMID: 28258514
- Data indicate cellular E3 ubiquitin ligase ring-finger and CHY zinc-finger domain-containing 1 (RCHY1) as an interacting partner of the viral SARS-unique domain (SUD) and papain-like protease (PL(pro)), and, as a consequence, the involvement of cellular p53 as antagonist of coronaviral replication. PMID: 27519799
- p27 and its cognate ubiquitin ligases, Skp2/KPC/Pirh2, are specifically involved in determining the clinical profiles of lung carcinomas. PMID: 28601655
- Decrease of PIRH2 expression in the breast cancer cell line MDA-MB-231 resulted in reduced tumor cell growth via the inhibition of cell proliferation and the interruption of cell cycle transition. PMID: 27393961
- The Hoxa2-mediated decay of RCHY1 involves both the 19S and 20S proteasome complexes PMID: 26496426
- Tumor suppressor p63 regulates expression of ubiquitin ligase PIRH2. PMID: 26995965
- Overexpression of Pirh2 decreased the replication of prototype foamy virus, whereas knockdown of Pirh2 with specific siRNA increased PFV replication. PMID: 25848801
- Pirh2 has a physiologically relevant role in keratinocyte differentiation through the posttranslational modification of p63 protein. PMID: 23235527
- suggested that the interaction of SCYL1BP1/Pirh2 could accelerate Pirh2 degradation through an ubiquitin-dependent pathway. SCYL1BP1 may function as an important tumor suppressor gene in HCC development PMID: 22570270
- Compared to full-length PIRH2A, PIRH2E lacks amino acids 235-261, while PIRH2F is missing C-terminal amino acids 227-261 and both isoforms harbor the RING domain. PMID: 22766706
- low expression of human PIRH2 in lung, ovarian, and breast cancers correlates with decreased patients' survival PMID: 22125490
- Data show that Pirh2 monoubiquitinates PolH at one of multiple lysine residues, and that monoubiquitination of PolH inhibits its ability to interact with PCNA and bypass UV-induced lesions, leading to decreased viability. PMID: 21791603
- Pirh2 promotes the proteasomal turnover of TAp73, and thus targeting Pirh2 to restore TAp73-mediated growth suppression in p53-deficient tumors may be developed as a novel anti-cancer strategy. PMID: 21852228
- identified a novel Pirh2-interacting protein, AIG1, by yeast two-hybrid screening and confirmed its interaction with p53 both in vitro and in vivo PMID: 21622095
- Our results suggest that Pirh2 mediates the degradation of p27(Kip1) and participates in cell proliferation in human hepatocellular carcinoma PMID: 21236467
- This comprehensive analysis of the Pirh2 and Mdm2 RING domains provides structural and mechanistic insight into p53 regulation by its E3 ligases. PMID: 21084285
- MDM2, MDMX, Pirh2 and COP1 might inhibit p53 activity synergistically in vivo. PMID: 20333547
- SCYL1-BP1 can be ubiquitinated and degraded by Pirh2 but not by MDM2, which suggests that SCYL1-BP1 can be regulated by Pirh2. PMID: 20598683
- low level of expression of hPirh2 was found both at transcriptional and translational level in human hepatocellular carcinoma (HCC) when compared to non-cancerous tissue. The protein shows no ubiquitin protein ligase activity. PMID: 20452352
- found that DNA polymerase eta is recruited by Pirh2 and degraded by 20S proteasome in a ubiquitin-independent manner. PMID: 20008555
- increased expression of PIRH2 was correlated with poor survival in patients with hepatocellular carcinoma; PIRH2 is a novel prognostic marker for hepatocellular carcinoma PMID: 19551892
- expression of measles virus antigens in non-small cell lung carcinoma is associated with expression of Pirh2. The presence of Pirh2 itself was associated with improved survival. PMID: 19895323
- cloning and characterization of an androgen receptor N-terminal-interacting protein with ubiquitin-protein ligase activity [androgen-receptor N-terminal-interacting protein; hARNIP] PMID: 12200228
- This protein is a p53-induced ubiquitin-protein ligase which promotes p53 degradation. PMID: 12654245
- These results are consistent with the hypothesis that increased Pirh2 expression affects lung tumorigenesis by reducing p53 activity. PMID: 15547185
- Human PIRH2 as a key modulator of AR function, opening a new direction for targeted therapy in aggressive human prostate cancer. PMID: 16914734
- Study evaluated Pirh2, MDM2, p53 and p21 expression after DNA damage using cancer cell lines with wildtype, mutant and null p53 and found that unlike MDM2, Pirh2 expression was not affected by wildtype p53 in the cancer cells. PMID: 16934800
- phosphorylation of Pirh2 may act as a fine-tuning to maintain the balance of p53-Pirh2 autoregulatory feedback loop, which facilitates the tight regulation of p53 stability and tumor suppression PMID: 17568776
- PIRH2 functions as a regulator for COP I complex. PMID: 17721809
- Given the importance of Pirh2 in regulating p53 stability, its interaction with PLAGL2 may provide valuable therapeutic targets in treating Pirh2-overexpression malignancies. PMID: 17950244
- Pirh2 acts as a negative regulator of p27(Kip1) function by promoting ubiquitin-dependent proteasomal degradation PMID: 18006823
- The authors show that Pirh2-p53 interaction is dependent on the C-terminal zinc binding module of Pirh2, which binds to the tetramerization domain of p53. PMID: 19043414
- The RCHY1 protein was displayed an unexpected role in regulating the organization of the network of K8/18 keratin filaments. PMID: 19282868
- Pirh2 overexpression may have an important role in the development and maintenance of head and neck squamous cell carcinoma at least partially through p27 degradation PMID: 19445020
- Pirh2 ubiquitin ligase has two novel isoforms that negatively regulate p53 independent of RING finger domains PMID: 19483087
- Pirh2 (ZNF363), a gene regulated by p53, encodes a RING-H2 domain-containing protein with intrinsic ubiquitin-protein ligase activity. Pirh2 protein physically interacts with p53 and promotes ubiquitination and degradation of p53 independently of Mdm2. PMID: 12654245
顯示更多
收起更多
-
亞細胞定位:Nucleus. Nucleus speckle. Cytoplasm.
-
數據庫鏈接:
Most popular with customers
-
YWHAB Recombinant Monoclonal Antibody
Applications: ELISA, WB, IHC, IF, FC
Species Reactivity: Human, Mouse, Rat
-
Phospho-YAP1 (S127) Recombinant Monoclonal Antibody
Applications: ELISA, WB, IHC
Species Reactivity: Human
-
-
-
-
-
-